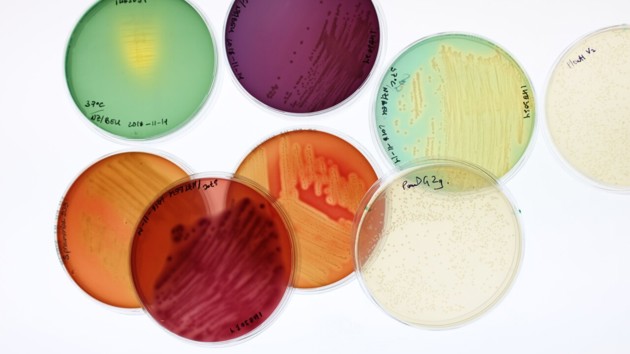

MIMS Spotlight Series: Nóra meets Björn Schröder
Björn Schröder joined the Laboratory for Molecular Infection Medicine Sweden, MIMS, in 2019 as a group leader. Nóra Lehotai had a chat with him to get to know how more about his research, how he ended up in Umeå and what he likes to do when he is not at work.
Published: 2022-01-20 Updated: 2023-06-13, 13:49 Text: Nóra Lehotai

Björn Schröder, research fellow at the Department of molecular biology and affilietad to MIMS.
ImageMattias PetterssonBjörn Schröder was born in Germany and has lived in France, in sunny California and of course, in Sweden and Germany. He shares his adventures with his wife.
Can you tell us about your role at MIMS, what are you working with?
“I am a group leader at MIMS and together with my amazing team we are interested in the interaction between diet, gut microbiota and the mucosal barrier in the intestine. Specifically, we focus on mucus and antimicrobial peptides, which are two important defence systems of the gut to prevent infections and microbial translocation of the gut bacteria into the body. In the group we use in vivo, ex vivo and in vitro studies to better understand how the mucosal barrier and the microbiota influence each other, since it seems that a specific microbial community is required to keep the defence systems active and functional.”
“Intestinal defence is impaired in inflammatory bowel diseases and metabolic diseases and appears to depend on the gut microbiota, so we try to identify how the microbiota can be used to strengthen the intestinal barrier to prevent or treat these diseases.”
What were you doing before you joined MIMS and what attracted you to start a position here?
“Before coming to Umeå, I have been working at Gothenburg University in the lab of professor Fredrik Bäckhed with a focus on gut microbiota and metabolic diseases. This is where I became interested in the gut microbiota and their relationship to diet. A close collaboration in Gothenburg with the Mucin biology groups attracted me to intestinal mucus function, and now here at MIMS I combine those interests with my previous research on antimicrobial peptides, which I worked on during my PhD thesis. This position here at MIMS was attractive to me because of the great start-up support, the research environment on infection biology, and also the collaborative working atmosphere here in Umeå.”

Björn Schröder likes the Swedish winters.
ImagePrivatIf you did not have your current profession, what do you think you would be doing?
“That’s a good question. I am interested in many different things, and one of them is fermenting microorganisms and their products. I am hosting a water kefir for more than 4 years now at home, from which we produce and drink about 10 liters per week. I could imagine doing this in a larger scale, as it is a pretty healthy probiotic drink. Also, I like scientific writing, so I could also picture something in that direction.”
What do you do in your free time and how do you like living in Umeå?
“I really like the change of seasons, with the cold and dark winters and the bright summers, which are also comparably mild. I recently learned cross-country skiing which I enjoy doing in the winter. And of course, watching the Northern lights from my window.”
“In the summer I like being out in the nature, either with a SUP on nearby lakes or in the nearby forests. It is great that everything is pretty close here within biking distance – I bike year-round – so that one can stay active even without going to the gym every day.”
Tell us something we might no know about you!
“Well, many people probably don’t know that I have jumped out of planes more than 10 times and once from a 111m high bridge – on a parachute or bungee rope, of course.”
Infection biology
Umeå University is at the international forefront in the research area of infection biology.

Department of Molecular Biology
The Department is affiliated to both the Faculty of Science and Technology and to the Faculty of Medicine.

Björn Schröder lab
Gut microbiota and intestinal mucosal barrier function.







